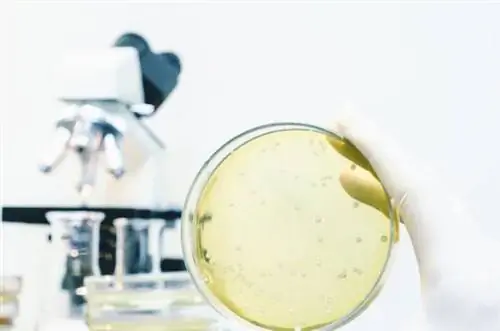
Гадюки в Балтийском море могут привести к летальному исходу. Симптомы стафилококковой инфекции

Обыкновенные бактерии - плотоядные бактерии, обитающие в тропических водах, но в течение нескольких лет они все чаще появляются и в Балтийском море. Все из-за глобального потепления. Людям, отдыхающим у моря, следует быть особенно осторожными, так как контакт с вибраторами может закончиться тяжелым пищевым отравлением, ампутацией конечности и даже смертью. Узнайте, где еще есть вибраторы и как их получить.
Обычные бактерииштаммVibrio vulnificus- этоплотоядные бактерии,которые обычно встречаются в тропических воды. Однако уже несколько лет все чаще и чаще появляетсяв Балтийском море, которое принято считать холодным морем. Все из-за потепления климата, из-за которого в действительно жаркие дни вода в Балтийском море намного теплее обычного.
В летний сезон 2019 года - до начала августа - в Германии зарегистрировано 5 случаев заражения этими бактериями. Один из них оказался смертельным - пожилая женщина скончалась после купания в Балтийском море в немецкой земле Макленбург-Передняя Померания. Общее число заболевших в Прибалтике в предыдущие годы не превышало нескольких десятков человек. Как будет в этом году? Это зависит от погоды.
Уже в 2012 году международная группа исследователей «Изменение климата в природе» утверждала, что польское море является самой быстро нагревающейся морской экосистемой в мире. В 1982-2010 годах температура воды в Балтийском море повышалась на 0,063-0,078 градуса Цельсия в год (в возрастной шкале это 6,3-7,8 градуса), а летом уже давно превышает 20 градусов. Цельсия.
Штамм Vibrio vulnificus интенсивно размножается именно тогда, когда температура воды превышает 20 градусов Цельсия. Более того, они распространяются тем быстрее, чем теплее вода - повышение температуры на каждый градус означает увеличение числа инфекций почти на 200 процентов. На развитие этих хищных батарей в Балтийском море также влияет уменьшение солености вод. Причиной этого являются частые дожди, которые также вызваны потеплением климата.
Запятая - как можно заразиться?
Заражение Vibrio vulnificus чаще всего происходит, когда человек с поврежденной кожей купается в воде, колонизированной бактериями, или отдыхает на пляже. Поэтому не стоит заходить в море, если на теле есть царапины или порезы, через которые в организм могут попасть бактерии. Стоит знать, что люди, живущие ок.50 км от побережья Балтийского моря.
Обычными бактериями можно заразиться не только во время плавания или занятий водными видами спорта, но и при употреблении зараженной рыбы и морепродуктов. Эти бактерии обнаружены в в креветках и устрицах.
Обычные бактерии - симптомы инфекции
Компоненты могут привести к пищевым отравлениям, а также воспалению желудка или кишечника. Эти заболевания могут вызывать различные недомогания со стороны пищеварительной системы - чаще всего
- боли в животе
- тошнота
- рвота
- лихорадка
Стрептококк также может вызывать целлюлит. Затем появится:
- сильное покраснение кожи, которая становится багровой
- боль
- выпечка
Сопутствующие симптомы - головная боль, тошнота и лихорадка. Vibrio vulnificus также вызывает некротизирующий фасциит, острую инфекцию подкожной соединительной ткани, которая часто приводит к ампутации.
Важно
Запятая может быть фатальной
Штамм Vibrio vulnificus особенно опасен для людей с ослабленным иммунитетом, т.к. дети, пожилые люди, а также те, кто борется с хроническими заболеваниями (например, диабетом) или борется с простудой. Однако наблюдения показывают, что больше всего риску заражения подвержены люди с хронической печеночной недостаточностью.
У этих людей вибрионы могут привести к опасным для жизни инфекциям, таким как сепсис, синдром системной воспалительной реакции.
Смертность от инфекции Vibrio vulnificus составляет около 25%. При развитии сепсиса летальность возрастает до 50%. Большинство пациентов, у которых развивается сепсис, обычно умирают в течение 48 часов после заражения.
Коммонс - лечение
Оптимальное лечение стафилококковой инфекции не установлено. Американская медицинская ассоциация (AMA) и Центры по контролю и профилактике заболеваний (CDC) рекомендуют давать пациентам внутривенно антибиотики хинолонового ряда.
Обычные также могут вызывать холеру
Vibrio vulnificus происходит из того же семейства, что и вызывающие холеру бактерии Vibrio cholerae. Эта бактерия распространена в основном в странах с низкими гигиеническими и санитарными нормами. Его основным переносчиком является вода.
